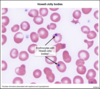

UWSA1-2 Flashcards
A 67-year-old man comes to the emergency department due to progressive weakness and numbness in his feet over the past month. The patient has had difficulty maintaining balance when walking and reports generally feeling weak. He has a history of alcohol use disorder and has been hospitalized for alcohol intoxication. Neurologic examination shows decreased tactile and vibratory sensation in the feet and ankles bilaterally. Gait is unsteady, and muscle strength is mildly decreased in both lower extremities. Lower extremity deep tendon reflexes are hyperactive, and Babinski sign is present bilaterally. Which of the following is the most likely cause of this patient’s current neurologic symptoms?
Cobalamin Deficiency
Subacute Combined Degeneration pathophysiology
The constellation of progressive neurologic symptoms and upper motor neuron signs (eg, hyperreflexia, Babinski sign) is suspicious for subacute combined degeneration. This myelopathy affects both ascending and descending pathways in the spinal cord and is associated with vitamin B12 (cobalamin) deficiency.
Vitamin B12 is a water-soluble vitamin found in animal-derived foods. Although liver stores are generally sufficient for several years, vitamin B12 deficiency can develop over time in patients with consistently poor intake (eg, strict vegan diet) or poor absorption (eg, pernicious anemia, chronic alcohol use).
Vitamin B12 is essential for DNA synthesis and repair, as well as myelin generation and maintenance (via methylation of neuronal lipids/proteins). Therefore, deficiency usually manifests with hematologic (eg, megaloblastic anemia) and/or neurologic abnormalities. Axonal damage within the spinal cord and peripheral nervous system is associated with motor and sensory deficits:
Dorsal columns: diminished tactile/vibratory sensation and proprioception (Romberg sign)
Lateral corticospinal tracts: muscle weakness, hyperreflexia, Babinski reflex, spastic paresis
Spinocerebellar tracts: diminished proprioception, sensory ataxia
Peripheral nervous system: paresthesia
For most patients, neurologic recovery following vitamin B12 supplementation is slow and variable.
Subacute Combined Degeneration S&S
- The constellation of progressive neurologic symptoms and upper motor neuron signs (eg, hyperreflexia, Babinski sign) is suspicious for subacute combined degeneration. This myelopathy affects both ascending and descending pathways in the spinal cord and is associated with vitamin B12 (cobalamin) deficiency.
- Vitamin B12 is essential for DNA synthesis and repair, as well as myelin generation and maintenance (via methylation of neuronal lipids/proteins).
- deficiency usually manifests with hematologic (eg, megaloblastic anemia) and/or neurologic abnormalities.
- Axonal damage within the spinal cord and peripheral nervous system is associated with motor and sensory deficits:
- Dorsal columns: diminished tactile/vibratory sensation and proprioception (Romberg sign)
- Lateral corticospinal tracts: muscle weakness, hyperreflexia, Babinski reflex, spastic paresis
- Spinocerebellar tracts: diminished proprioception, sensory ataxia
- Peripheral nervous system: paresthesia
Subacute Combined Degeneration Tx
For most patients, neurologic recovery following vitamin B12 supplementation is slow and variable.
Amyotropic Lateral Sclerosis vs Subacute Combined Degeneration
Amyotrophic lateral sclerosis is a neurodegenerative disorder that affects both upper and lower motor neurons and often presents with asymmetric limb weakness and incoordination. However, sensory pathways are rarely affected, and loss of tactile/vibratory sensation would be unexpected in Subacute Combined Degeneration.
Cerebellar Degeneration vs Subacute Combined Degeneration
Cerebellar degeneration in patients with extensive alcohol use is caused by damage to Purkinje cells in the cerebellar cortex and can lead to gait impairment (incoordination similar to that seen in alcohol intoxication). However, tactile/vibratory sensation loss and upper motor neuron signs (eg, hyperreflexia, Babinski reflex) would not be expected.
Subacute Combined Degeneration vs Thaimine Deficiency
Thiamine deficiency can cause peripheral neuropathy leading to gait impairment; thiamine deficiency can also cause Wernicke encephalopathy (ie, ataxia, confusion, oculomotor dysfunction).
However, SCD neurologic symptoms include upper motor neuron signs (eg, hyperreflexia, Babinski reflex), which are not seen with thiamine deficiency.
Vitamin B12 role in Subacute combined Degeneration
Vitamin B12 (cobalamin) deficiency can cause subacute combined degeneration of the spinal cord due to impaired myelination in the dorsal columns (causing diminished tactile/vibratory sensation and proprioception) and lateral corticospinal tracts (causing hyperreflexia, Babinski reflex, spastic paresis).
Myasthenia gravis Pathophysiology
- Autoantibodies against acetylcholine receptors at motor endplate
- Thymus involved in autoimmunity:
- Thymic hyperplasia
- Thymoma
myasthenia gravis (MG), an autoimmune disease that affects acetylcholine receptors (AChRs) in the postsynaptic membrane of the neuromuscular junction. Thymic abnormalities are extremely common in patients with MG and include thymic hyperplasia or thymomas. The thymus is thought to be the site of autoimmunization in MG and contains muscle-like cells that express AChRs. Abnormal antigen-presenting cells within the thymus process AChRs, allowing for priming of helper T cells and recruitment of B cells to form AChR antibodies. This leads to a decrease in the number of functional AChRs with resultant fatigable musculoskeletal weakness.
Myasthenia Gravis S&S
- Fluctuating & fatigable proximal muscle weakness; worse later in the day
- Ocular (eg, diplopia, ptosis)
- Bulbar (eg, dysphagia, dysarthria)
- Respiratory muscles (eg, myasthenic crisis)
intermittent diplopia, bulbar muscle weakness (eg, fatigue with chewing), and ptosis on examination likely has myasthenia gravis (MG)
Edrophonium test
A Tensilon test is a diagnostic test used to evaluate Myasthenia Gravis, which is a neuromuscular condition characterized by auto anti motor endplate acethylcholine receptor antibodies muscle weakness. The test involves an injection of Tensilon (edrophonium), after which your muscle strength is evaluated to determine whether your weakness is caused by myasthenia gravis or not.
Tensilon reverses the symptoms of myasthenia gravis. It works by preventing your acetylcholine from breaking down. It inhibits the enzyme that normally breaks down acetylcholine, acetylcholinesterase, allowing your acetylcholine to bind to the existing receptors as much as possible.
Improved weakness is a positive test for myasthenia gravis
Ice pack test
A test to check for Myasthenia Gravis
An ice pack is applied to the ptotic lid for 2 minutes, and ptosis is measured with a ruler before and after cooling. A rise of 2 mm is a positive result indicating Myasthenia Gravis
Myasthenia Gravis Tx
- Acetylcholinesterase inhibitors (eg, pyridostigmine)
- Thymectomy
Myasthenia Gravis Serology
anit acetylcholine receptor antibodies (AChRs) in the postsynaptic membrane of the neuromuscular junction

Thymoma

Lambert-Eaton myasthenic syndrome (LEMS) Pathophysiology
an autoimmune disorder of the neuromuscular junction caused by antibodies against voltage-gated calcium channels on the presynaptic membrane.
Lambert-Eaton Myasthenic syndrome Vs Myasthenia Gravis
LEMS resembles MG, but the weakness lessens rather than worsens with repeated stimulation and the limbs are typically affected more than the bulbar muscles.
Pituitary Adenoma common Presentation
Pituitary adenomas most often present with bitemporal hemianopsia (compression of the optic chiasm), headache (mass effect), and diplopia (oculomotor nerve compression). Hormone abnormalities (eg, hyperprolactinemia, Cushing disease, acromegaly) can also be seen.
Myasthenia Gravis Brief Description
Myasthenia gravis is an autoimmune disease that affects the postsynaptic acetylcholine receptors of the neuromuscular junction and presents with fatigable musculoskeletal weakness (particularly eye and bulbar musculature). Thymic abnormalities (hyperplasia, thymomas) are extremely common in patients with myasthenia gravis; patients often improve with thymectomy.
Retinoblastoma white reflex

Retinoblastoma Pathopgenesis
- The retinoblastoma (RB1) gene, a tumor suppressor gene that, when defective, predisposes to retinoblastoma.
- One copy of the RB1 gene is found on each chromosome 13.
- Both copies of the RB1 gene must be lost for tumorigenesis to occur. This concept reflects the Knudson “2-hit” hypothesis of tumorigenesis.
- Patients with sporadic retinoblastoma develop 2 spontaneous somatic mutations in a single retinal cell, resulting in a unilateral tumor.
- In contrast, patients with hereditary retinoblastoma are born with a germline defect in one of their RB1 genes. As a result, all their cells have the first “hit” required for tumor formation. An additional somatic mutation (eg, a loss of heterozygosity) early in life provides the second “hit” for malignant transformation.
- Patients with hereditary retinoblastoma are at increased risk for bilateral and multifocal retinoblastoma. They are also at risk for development of other primary malignancies, such as osteosarcoma, later in life.
Xeroderma Pigmentosum pathophys
- Defective DNA repair occurs in xeroderma pigmentosum, a heritable disease resulting from defective nucleotide excision repair that predisposes to early skin cancer of all forms
Partial Hydatidiform moles karyotype
Partial hydatidiform moles result from triploidy
(69XXX,
69XXY,
or
69 XYY)
What is this?
Joint aspirate

Septoc Arthritis

Septic Arthritis common causal organsisms
The most common causative organisms are:
- Staphylococcus aureus
- Neisseria gonorrhoeae
- Streptococcus
- Haemophilus influenzae
and gram-negattrive bacilli
- Escherichia coli,
- Salmonella,
- Pseudomonas
Most common cause of Septic Arthritis in children < 2
Children younger than age 2 years are especially vulnerable to H influenzae arthritis
Most common cause of septic arthritis in children >2 and adults
children older than > 2 and adults tend to develop S aureus arthritis
Septic Arthiritis features
- This patient has knee pain, an effusion, and synovial fluid with numerous polymorphonuclear leukocytes and cocci, a combination that is indicative of joint infection (septic arthritis). Septic arthritis can sometimes develop following trauma.
- The presence of numerous polymorphonuclear leukocytes and bacteria in the joint space indicates infection. Some of the most common causative organisms of infectious arthritis are Staphylococcus aureus and Neisseria gonorrhoeae.
Most common septic arthritis in adolesences and young adults
During late adolescence and early adulthood, N gonorrhoeae arthritis is particularly common (especially in women)
Most common septic arthritis in sickle cell disease and trait patients
Salmonella
Characteristic features of osteoarthritic joint
cartilage wear-and-tear, bony eburnation, dislodging of cartilage and bone pieces (“joint mice”), fibrous-walled cysts within the subchondral bone, and bony outgrowths at the articular margins
Characteristics of joint affected by gout
Characteristic features of a joint affected by gout include monosodium urate crystals that are slender, needle-shaped, and negatively birefringent.

Characteristics of joint affected by Rheumatoid Arthritis
Characteristic features of a joint affected by rheumatoid arthritis include immune complex deposition, neutrophil accumulation in the synovial fluid (without bacteria), perivascular inflammation of the synovial stroma, bone erosion, and pannus formation
Characteristics of a traumatic joint injury
The characteristic feature of traumatic joint injury is a joint effusion that may be serosanguineous or frankly bloody.
What is this?


Di George Syndrome AKA
Velocardiofacial Syndrome
or
Chromosome 22q11.2 deletion
Di George Syndrome pathogenesis
DiGeorge syndrome is primarily a T-cell deficiency characterized by deletions on chromosome 22q11.
This syndrome results from the failed development of the third and fourth pharyngeal pouches (predecessors of the thymus, parathyroid glands, and ultimobranchial body).
Consequently, individuals with DiGeorge syndrome have impaired T cell-mediated immunity (secondary to an absent or hypoplastic thymus) and tetany (secondary to absent parathyroid glands).
Due to the hypoplastic or absent thymus, the fraction of B lymphocytes (CD20+) is adequate, but the circulating fraction of T lymphocytes (CD3+) is reduced. T cells are involved in the direct killing of viruses (cellular immunity) and in signaling B cells to develop into antibody-producing plasma cells (humoral immunity).
As a result, patients with T-cell deficiency are susceptible to recurrent viral, bacterial and fungal (eg, Candida, Pneumocystis jiroveci) infections.
Digeorge Flow cytometry
Flow cytometry shows low CD3+ (T cell) fraction but a normal CD20+ (B cell) fraction.
Digeorge Syndrome Clinical Features
- Conotruncal cardiac defects (tetralogy of Fallot, truncus arteriosus, interrupted aortic arch)
- Abnormal facies
- Thymic hypoplasia/aplasia (T-cell deficiency and so impaired B cell isotype switching)
- Craniofacial deformities (cleft palate)
- Hypocalcemia/Hypoparathyroidism
Digeorge Syndrome Pharyngeal pouches
failed development of the third and fourth pharyngeal pouches
β-2 integrin defect
A defect in β-2 integrin (an adhesion molecule) prevents phagocytes from adhering and migrating across the endothelium. Patients present with severe leukocytosis, delayed separation of the umbilical cord, sterile abscesses, and poor wound healing.
Adenosine Deaminase Deficiency
which results in the buildup of toxic adenosine and deoxyadenosine within lymphoid cells.
It is characterized by recurrent bacterial, viral, and fungal infections.
Both CD20+ and CD3+ levels will be low in affected patients.
Hyper IgM Syndrome pathophysiology
Hyper-IgM syndrome is an X-linked defect in the T-cell CD40 ligand (CD154), which is expressed by T lymphocytes.
This defect prevents effective B cell isotype (class) switching from IgM to other classes of immunoglobulins.
Absence of IgG production predisposes patients to development of recurrent infection with encapsulated bacteria (but not fungi).
Hyper IgM Syndrome Type 1 (HIGM-1) is the X-linked variant of the hyper IgM syndrome. The affected individuals are virtually always male, because males only have one X chromosome, received from their mothers. Their mothers are not symptomatic, even though they are carriers of the allele, because the trait is recessive.
CD40 Ligand deficiency
Hyper IgM Syndrome which is X-linked
Chronic Granulomatous Disease pathophysiology
Chronic granulomatous disease is an X-linked recessive disorder characterized by NADPH oxidase deficiency, which causes ineffective intracellular oxidative burst. Patients typically present with recurrent infections (eg, abscesses, pneumonia, osteomyelitis) due to Staphylococcus aureus, Burkholderia cepacia complex, Aspergillus, Serratia marcescens, and Nocardia.
Chronic Granulomatous Disease organisms
Catalase Positive Organisms
- Staphylococcus aureus
- Burkholderia cepacia complex
- Aspergillus
- Serratia marcescens
- Nocardia.
Chronic Granulomatous Disease S&S
- often appear in first year of life with recurrent pyogenic infections
- recurrent infection with catalase-positive organisms
- pneumonias
- aspergillosis
- skin abscesses
- pulmonary abscesses
- chronic diarrhea
- failure to thrive
Physical exam
- short stature
- eczematoid dermatitis
- hepatomegaly
Effects of Lack of insulin

A previously healthy, 6-year-old boy is brought to the emergency department due to abdominal pain. His mother reports that he has had nausea and vomiting, but no fevers, for the past two days. She also notes that the patient has been urinating more than usual and seems to be breathing heavily. Urine analysis is positive for ketones. Which of the following patterns of serum abnormalities is most likely to be seen in this patient?
Glucose:
Potassium:
Sodium:
Glucose: Increased
Potassium: Increased
Sodium: Decreased
Diabetic Ketoacidosis S&S
Patients with DKA can have polyuria, polydipsia, abdominal pain/tenderness, nausea, vomiting, fatigue, stupor, and/or tachypnea.
Diabetic Ketoacidosis MEtabolic Derangements mechanism
The metabolic derangements observed in DKA stem from insulin deficiency and include hyperketonemia, metabolic acidosis, hyperglycemia, hyperkalemia, and hyponatremia. Acidemia and carbohydrate depletion in smooth muscle cells can also cause painful dysmotility, distension, and ileus in the stomach and intestines. Administration of intravenous fluids and insulin can reverse the metabolic derangements in patients with DKA. Although serum potassium is normal or increased in DKA, total body potassium stores are actually paradoxically decreased due to urinary loss (ie, osmotic diuresis) and GI loss (ie, vomiting); therefore, these patients require potassium replacement during treatment.
Metabolic Derangements of Diabetic Ketoacidosis
Metabolic derangements associated with diabetic ketoacidosis include metabolic acidosis, ketonemia, hyperglycemia, hyperkalemia, and hyponatremia.
Although serum potassium is increased, total body potassium stores are decreased; consequently, patients require potassium replacement during treatment.

What is this depicting


A 22-year-old previously healthy man comes to the office due to paroxysmal occipital headaches for the past several months. The headaches are characterized as dull and graded 6/10 in intensity. The patient has also had episodic dizziness that is brought on by coughing or lifting heavy objects. His symptoms are interfering with his job as a construction worker. He has no history of head trauma, fever, nasal congestion, or hearing loss. Physical examination is unremarkable. MRI of the head is shown below.


Radiographic features of Arnold Chiari 1 malformation

downward displacement of cerebellar structures often associated with a small posterior fossa. Other features may include spinal cord defects (eg, syringomyelia, meningomyelocele) and non-communicating hydrocephalus due to cerebrospinal fluid outflow obstruction through the posterior fossa

Chiari Malformation pathogenesis
Chiari malformations (CMs) are congenital structural anomalies caused by defects in craniocervical and/or hindbrain development.
Arnold Chiari Malformation 1 features
Chiari I malformation is characterized by the downward displacement of elongated cerebellar tonsils through the foramen magnum and into the upper cervical canal. Patients often present during adolescence or adulthood with occipital headache and symptoms of cerebellar dysfunction that may worsen with Valsalva.
Chiari I malformation is the most common and mildest form of this condition and typically presents during adolescence or adulthood. Patients often have occipital headache (due to meningeal irritation) and cerebellar dysfunction (eg, dizziness) that may worsen with Valsalva (eg, coughing, lifting heavy objects) due to compression of the cerebellar tonsils. MRI of the head characteristically shows downward displacement of elongated cerebellar tonsils through the foramen magnum and into the upper cervical canal.

Agenesis of Corpus callosum
The corpus callosum connects the cerebral hemispheres. Agenesis of the corpus callosum is a rare congenital disorder that can be associated with Chiari or Dandy-Walker malformations.
Dandy-Walker Malformation
characterized by hypoplasia/absence of the cerebellar vermis and cystic dilation of the fourth ventricle with enlargement of the posterior fossa.

Holoprosencephaly description
Holoprosencephaly is characterized by incomplete development and separation of the embryonic forebrain (prosencephalon) and is often associated with midfacial defects
disorder of the brain occurring at 3-6 weeks’ gestation, with failed segmentation of the neural tube. This leads to incomplete separation of the prosencephalon (forebrain).
Spina bifida cystica AKA
Spina bifida cystica (myelomeningocele)
Spina bifida cystica description
Spina bifida cystica (myelomeningocele) is a neural tube defect that results in protrusion of the spinal cord and meninges through an unfused portion of the vertebral column. It is associated with Chiari II malformation, which typically presents in childhood.
Syringobulbia description
Syringobulbia is a fluid-filled cavity within the lower brainstem (eg, medulla)
Syringomyelia description
syringomyelia is a fluid-filled cavity within the spinal cord.
A 16-year-old girl comes to the office due to primary amenorrhea. She has never menstruated, but her sister and mother had menarche at age 14. The patient has been healthy and takes no medications. She plays varsity soccer in the fall and runs track in the spring. Examination shows Tanner stage 5 breasts and a vagina that ends in a blind pouch. A bulge is palpated in the left groin. Serum testosterone level is 900 ng/dL (normal: 15-75 for female patients, 300-1000 for male patients). Which of the following is the most likely cause of this patient’s condition?
X-linked Defect of androgen receptor
Complete Androgen Insensitivity Syndrome pathophysiology
- X-linked Recessive mutation of androgen receptor
- results in normal-appearing female with male genotype 46, XY
- Loss of negative feedback results in ↑ testosterone and LH
- ↑ estrogen due to conversion of excess testosterone via aromatase
- Y chromosome contains the sex determining region of Y (SRY) encodes the gene for Müllerian Inhibitory Factor (MIF) produced by Sertoli cells
- MIF secretion results in degeneration of internal female sex organs
- The lack of androgen receptor results in lack of developing male genitalia as well as secondary sexual characterisitics
Complete Androgen inSensitivity Syndrome Phenotype
- Breasts developed (free testosterone aromatized to estrogen resulting in breast development)
- Absent Uterus or ovaries
- Absent upper Vagina
- Cryptorchid Testes
- No penis/scrotum
- Minimal to absent pubic hair
- 46, XY

5-α Reductase Deficiency pathophysiology
- Nonfunctional enzyme to convert testosterone to DHT
- Autosomal recessive defect in 5α-reductase in XY males -> impaired conversion of testosterone to dihydrotestosterone (DHT)
- leads to impaired virilization during embryogenesis
- normal testosterone production and normal estrogen levels
- normal or elevated LH
- normal internal genitalia
- ambiguous genitalia until puberty, where elevated testosterone levels leads to masculinization
- DHT plays an important role in the development of the external genitalia
- also primary androgen for the prostate gland
Complete Androgen inSensitivity Syndrome karyotype
46, XY
Role of DHT in Sexual development
- DHT plays an important role in the development of the male external genitalia
- also primary androgen for the prostate gland
Anti-müllerian hormone function in sexual development
AMH causes regression of the müllerian structures (eg, uterus, cervix, upper third of the vagina); therefore, female internal genitalia do not develop.
anti-müllerian hormone is secreted by?
Sertoli Cells
5-α Reductase Deficiency phenotype
- No breasts
- Absent uterus and ovaries
- Cryptorchid Testes
- Ambiguous genitalia at birth with virulization during puberty
- 46, XY
Müllerian Agenesis description
Hypoplastic or absent Müllerian ductal system
Müllerian agenesis causes primary amenorrhea because the uterus, fallopian tubes, and proximal vagina fail to develop, resulting in a blind-ending vaginal pouch. However, the ovaries have a different embryologic origin than the müllerian structures; therefore, their development and function are not affected, and testosterone levels are within normal female range.
Müllerian agenesis is caused by embryologic underdevelopment of the müllerian duct, with resultant agenesis or atresia of the vagina, uterus, or both
46, XX with intact ovaries
Müllerian Agenesis AKA
Mayer-Rokitansky-Kuster-Hauser Syndrome
Müllerian Agenesis phenotype
- Normal breasts
- Absent or rudimentary uterus & upper vagina
- Normal ovaries
Müllerian agenesis S&S
Symptoms
- primary amenorrhea
- normal development of secondary sexual characteristics, including thelarche and adrenarche
Physical exam
- complete or partial absence of the cervix, uterus, vagina
Turner Syndrome pathogenesis
Turner syndrome (45,X) results from loss of the paternal X chromosome during gametogenesis
X Monosomy resulting from:
- nondisjuction (XO)
- mosaicism (XX, XO; XY, XO)
Leading to ↓ estradiol leads to ↑ FSH and LH
normal GH and insulin-like growth factor
only monosomy not aborted in utero
no Barr bodies
Turner Syndrome S&S
Leads to abnormal sexual differentiation with
- primary amenorrhea
- streak gonads
- menopause before menarche
- infertility
- delayed sexual maturation
- normal intellegence
Physical Exam
- short stature
- webbed neck
- shield chest
- wrist and ankle edema
- both edema and webbed neck a result of malformed lymphatic vasculature
The only monosomy not aborted in utero
Turner Syndrome
Turner Syndrome increased risk of . . .
6 Listed
- gonadal blastoma (specifically XY, XO mosaics, as Y chromosome increases risk of tumor formation in dysgenic gonads)
- preductal coarctation of aorta
- bicuspid aortic valve
- dysgerminoma ovarian tumor
- horseshoe kidney
- decreased fertility
Process of female undifferentiated gonad development

Process of male undifferentiated gonad development

Congenital Adrenal Hyperplasia description
- Congenital adrenal hyperplasia is most commonly caused by 21-hydroxylase deficiency and presents with life-threatening salt wasting in infants.
- Affected girls can have ambiguous genitalia due to increased adrenal androgen production; however, development of müllerian structures is normal and they have a uterus.
5-α Reductase Deficiency Description
- 5-Alpha reductase deficiency is an autosomal recessive disorder causing impaired testosterone to dihydrotestosterone (DHT) conversion.
- Affected males are typically undervirilized (eg, predominantly female, clitoromegaly) and have an increased serum testosterone/DHT ratio.
- However, breast development does not occur due to the inhibitory effect of circulating testosterone (which is able to activate the testosterone receptor, unlike in patients with AIS)
α1 agonist examples
- Miodrine
- Phenylephrine
α1 agonist effect on heart rate
Decrease (reflex)
α1 agonist effect on Contractility
Decrease (reflex)
α1 agonist effect on SVR
Increase
α2 agonist examples
Clonidine
α2 agonist Effect on HR
Decrease (via central receptors)
α2 agonist effect on Cardiac contractility
None
α2 agonist effect on SVR
Decrease (via central receptors)
α1 antagonist examples
- Doxazosin
- Terazosin
α1 antagonist effect on HR
Increase (reflex)
α1 antagonist effect on cardiac contractility
None
α1 antagonist effect on SVR
Decrease
α1/α2 antagonist examples
Phenoxybenzamine
α1/α2 antagonist effect on HR
Increase (reflex)
α1/α2 antagonist effect on contractility
None
α1/α2 antagonist effect on SVR
Decrease
non-selective β agonist examples
Isoproterenol
non-selective β agonist HR
Increase
non-selective β agonist contractility
Increase
non-selective β agonist effect on SVR
Decrease (via β2 agonist effect)
β1 antagonist examples
- Metoprolol
- Atenolol
β1 antagonist HR
Decrease
β1 antagonist Contracility
Decrease
β1 antagonist SVR
None
Pheochromocytoma pathogenesis
Arises from neuroendocrine cells in adrenal medulla
25% inherited:
- VHL gene (von Hippel-Lindau)
- RET gene (multiple endocrine neoplasia type 2)
- NF1 gene (neurofibromatosis)
Symptoms result from increased catecholamine secretion
Pheochromocytoma S&S
- Headache
- Tachycardia/palpitations
- Sweating
- Hypertension
Pheochromocytoma Rule of 10s
- 10% bilateral
- 10% extraadrenal (paragangliomas)
- 10% malignant
Pheochromocytoma Dx
Elevated urinary & plasma catecholamines & metanephrines
Pheochromocytoma Description
a catecholamine-secreting (eg, epinephrine, norepinephrine, dopamine) tumor of chromaffin cells of the adrenal medulla. Patients also frequently experience severe, paroxysmal hypertension due to stimulation of peripheral vascular alpha-adrenergic (predominantly alpha- 1) and renal beta-1 receptors (increasing renin release). Surgical resection (adrenalectomy) is curative, but induction of anesthesia and manipulation of the gland can trigger intraoperative hypertensive crisis due to sudden release of catecholamines.
To prevent this, patients should receive pharmacologic alpha- and beta-adrenergic blockade prior to surgery. Phenoxybenzamine is an irreversible, long-acting alpha-adrenergic blocker that prevents peripheral vasoconstriction. Beta blockers (eg, propranolol, metoprolol) can be added to further control hypertension and reduce reflex tachycardia. However, beta blockade should never be initiated first because unopposed alpha-adrenergic stimulation (in the absence of beta-2 vasodilation) can cause severe vasoconstriction and lead to a life-threatening hypertensive crisis
Adrenal Crisis Tx
Glucocorticoids (eg, hydrocortisone) are used to treat adrenal crisis, which can be precipitated by surgery in patients with adrenal insufficiency (hypotension, weakness).
Carcinoid Tumor hormone blockade during surgery
Carcinoid tumors are neuroendocrine neoplasms that can secrete large amounts of serotonin and related compounds. Hormone release during surgery can precipitate carcinoid crisis (flushing, hypotension, bronchospasm), which can be treated with infusion of octreotide
A 2-day-old boy was born at 25 weeks gestation by vaginal delivery to a 38-year-old woman who presented with preterm premature rupture of membranes. Apgar scores were 3 and 5 at 1 and 5 minutes, respectively. The infant was intubated in the delivery room and quickly transported to the neonatal intensive care unit for mechanical ventilation and ongoing management of severe respiratory distress due to surfactant deficiency. He develops a bulging fontanelle, intermittent apnea, and decerebrate posturing and dies. Autopsy reveals bilateral thrombi in the lateral ventricles. Which of the following is the most likely underlying cause of this patient’s condition?
Fragility of the germinal matrix
Intraventricular hemorrhage in infants pathogenesis
Premature infants are at significant risk for intraventricular hemorrhage (IVH), also known as germinal matrix hemorrhage.
The germinal matrix is a dense cellular and vascular layer of the subependymal zone of the brain from which neurons and glial cells develop in utero. The germinal matrix begins to involute at 28 weeks gestation and is absent by term. Unlike other parts of the brain, the vascular network of the germinal matrix is weak and lacking in structural support, which makes it vulnerable to spontaneous hemorrhage.
Although germinal matrix hemorrhage begins between the caudate nucleus and the thalamus, as the area of bleeding increases in size, it extends into the lateral, third, and fourth ventricles, often resulting in hydrocephalus (eg, bulging fontanelle).
Patients may be asymptomatic or develop seizures, altered mental status, and apnea. Clots can form in both the pre- and postmortem period due to hemorrhage and may be seen on autopsy.
Germinal matrix hemorrhage risk factors
The primary risk factor for IVH is physiologic immaturity; infants with very low birth weights (<1500 g [3.3 lb]) and those born preterm (especially <32 weeks gestation) are at greatest risk.
Any process that causes changes in cerebral blood flow (eg, respiratory distress, mechanical ventilation, cardiopulmonary resuscitation) also markedly increases the risk of IVH.
Kernicterus description
Kernicterus refers to permanent neurologic damage (eg, cerebral palsy) resulting from severe untreated hyperbilirubinemia in the neonatal period. Although preterm infants are at increased risk for hyperbilirubinemia due to immaturity of hepatic bilirubin conjugation, kernicterus appears as grossly yellow discoloration of the brain parenchyma (especially the basal ganglia) and does not cause intraventricular thrombi.
Cephalohematoma
Rupture of the subperiosteal blood vessels results in cephalohematoma. Cephalohematoma, which can occur after a traumatic birth (eg, forceps or vacuum delivery), presents as scalp swelling that does not cross sutures lines.

Subdural Hematoma Vs Epidural Hematoma

Subdural Hematoma results from
Ruptured bridging veins
Epidural Hematoma results from
rupture of middle meningeal artery
Intraventricular hemorrhage in infants S&S
- May be asymptomatic
- Seizures
- Altered mental status
Cisplatin and hearing loss
Certain medications have the adverse effect of causing tinnitus and hearing loss by damaging hair cells within the organ of Corti of the cochlear membranous labyrinth.
Electrophysiologic studies have shown that cisplatin primarily damages the apical stereocilia on hair cells. On audiogram, a subclinical loss of response to high frequencies occurs in 74–100% of patients receiving cumulative cisplatin doses of 200 mg/m2. Approximately 6% of patients receiving cisplatin develop clinical hearing loss, with children particularly at risk.
Etoposide Adverse effects
alopecia, gastrointestinal irritation, and myelosuppression
Doxorubicin (adriamycin) adverse effects
is associated with alopecia, myocardial damage, and myelosuppression.
Ondansetron Adverse effects
- headache
- constipation
Causes of Drug-induced Interstitial Lung disease
- Amiodarone
- Bleomycin
- Methotrexate
Causes of Interstitial Lung disease
Drugs (amiodarone, bleomycin, methotrexate)
connective tissue disease (RA, SLE, systemic sclerosis)
Environmental (silica, talc, fungi, animal proteins (bird fanciers lung)
Cryptogenic: idiopathic pulmonary fibrosis
Interstitial Lung disease S&S
Progressive dyspnea, dry cough, fatigue
Fine crackles during late inspiration, possible digital clubbing
Extrapulmonary signs of systemic disease (eg, skin thickening, butterfly rash)
Interstitial lung diseases Dx
- Chest X-ray: Reticular or nodular opacities
- Chest CT: Fibrosis or honeycombing
- PFTs: ↑FEV1/FVC; ↓DLCO, ↓TLC
Amidarone-induced Interstitial pneumonitis
Amiodarone, an antiarrhythmic sometimes used in atrial fibrillation, can cause a variety of pulmonary toxicities, but most commonly causes interstitial pneumonitis, which occurs in up to 5% of patients.
Amiodarone-induced interstitial pneumonitis (AIIP) typically presents with slowly progressive dyspnea, nonproductive cough, and occasional fever.
The condition is likely due to drug-induced cytotoxicity and is usually reversible with drug discontinuation. Other adverse effects of amiodarone include thyroid abnormalities, hepatic injury, and bluish-gray skin discoloration.
Misoprostol MOA
Misoprostol is a prostaglandin E1 analog (receptor agonist)
Misoprostol in abortions
is a prostaglandin E1 analog (receptor agonist) that can be used for abortion as it also causes uterine contractions and cervical ripening, leading to fetal loss
M3 receptor downstream signaling
+ IP3/Ca2+
Gastrin Receptor
CCKB Receptor
CCKB Receptor downstream signaling
+ IP3/Ca2+
H2 receptor downstream signaling
+ cAMP
Prostaglandin E receptor downstream signalling
- cAMP
Somatostatin receptor downstream signalling
- cAMP
Describe receptors and second messengers and effect on H+ secretion


Describe the Arachindonic acid pathway in NSAID-exacerbated respiratory disease
NSAIDs and Aspirins inhibit Cox-1 and Cox 2 preventing arachidonic acid from forming Prostaglandin H2 and later the anti-inflammatory and bronchodilators PGe2 and PGI2
so Arachidonic acid is shunted into the 5-lipoxygenase pathway forming leukotriene A4 and other leukotrienes which is proinflammatory and causes bronchospasm

Non-steroidal anti-inflammatory drug exacerbated respiratory disease pathogenesis
NERD results from the dysregulation of arachidonic acid metabolism due to cyclooxygenase inhibition.
Increased diversion of arachidonic acid down the 5-lipoxygenase pathway leads to increased formation of leukotrienes (eg, leukotrienes C4, D4, and E4), which stimulate bronchoconstriction and increased vascular permeability (airway edema).
Accordingly, leukotriene-receptor antagonists (eg, montelukast, zafirlukast) and 5-lipoxygenase inhibitors (eg, zileuton) are a mainstay of treatment for NERD.
NERD Tx
leukotriene-receptor antagonists (eg, montelukast, zafirlukast) and 5-lipoxygenase inhibitors (eg, zileuton) are a mainstay of treatment for NERD.
Zileuton MOA
5-lipoxygenase inhibitor
Histological features of Squamous Cell Carcinoma

Describe Variable Expression
This difference in phenotype is observed even among those who carry the same genetic mutation, a concept known as variable expressivity. Prediction of symptoms is challenging in conditions with variable expressivity, as the specific phenotype is often dependent on multiple interacting genetic and environmental factors
Genetic Anticipation
Genetic anticipation is used to describe an inherited disease state in which successive generations experience earlier onset or increased severity of the disease (eg, Huntington disease).
Genetic heterogeneity
Genetic heterogeneity describes a phenomenon in which a disease phenotype can be caused by one of several different genotypes. For example, osteogenesis imperfecta can result from mutations affecting either of the genes coding for type 1 collagen (eg, COL1A1, COL1A2).
Germline mosaicism
Germline mosaicism is a condition in which multiple sets of genetic information are found in the germ cells producing ova or sperm. It can result in mutations being passed to offspring even if the patient’s somatic (body) cells are unaffected.
Penetrance
Penetrance is defined as the proportion of people with a disease genotype who express the disease phenotype. When some individuals express a genotype but not the corresponding phenotype, the disease is said to show incomplete penetrance (eg, not all patients with BRCA gene mutations develop breast cancer).
stable angina description
squeezing retrosternal chest pain that is brought on by exertion is consistent with stable angina, which results from a mismatch of myocardial oxygen supply and demand in the setting of coronary artery disease (CAD).
Stable angina Tx with Nitrates
Medications that treat stable angina do so by either reducing myocardial oxygen demand and/or increasing myocardial oxygen supply.
Nitrates (eg, sublingual nitroglycerin, isosorbide dinitrate) improve stable angina symptoms primarily via a reduction in myocardial wall stress that leads to reduced myocardial oxygen demand.
This occurs via the induction of vascular smooth muscle relaxation primarily within the venous system. The resulting venodilation causes blood to pool in the venous capacitance veins, reducing venous return to the heart and decreasing left ventricular end-diastolic volume (ie, preload) to reduce myocardial wall stress.
Nitrates have no direct effect on cardiac inotropy or chronotropy, but relatively high doses can have a slight vasodilatory effect on arterioles, which may induce a drop in blood pressure that is compensated by a reflexive increase in heart rate. Care must be taken to avoid a significant increase in heart rate because the resulting increase in myocardial oxygen demand may overcome the reduction in myocardial oxygen demand obtained from reduced wall stress (patients with CAD are usually taking beta blockers, which help minimize a reflexive increase in heart rate).
A 2-year-old girl is evaluated in the office for frequent, foul-smelling diarrhea and oily stools that float. Review of her growth chart indicates poor weight gain. Examination shows a thin, short toddler with bilateral wheezing and crackles on lung auscultation. An inherited defect involving the cystic fibrosis transmembrane conductance regulator (CFTR) protein is suspected. Sodium and chloride body fluid levels (relative to normal) are as follows:
Sodium concentration Chloride concentration
Sweat high high
Bronchial low low
secretions
Which of the following best explains the difference in electrolyte findings between the 2 types of body fluids?
Difference in tissue-specific functioning in CFTR
CFTR function in Sweat Ducts vs Respiratory mucosa
In the eccrine sweat glands, CFTR acts to reabsorb chloride from sweat fluid and also enhances sodium reabsorption by the epithelial sodium channel (ENaC). As a result, mutated CFTR diminishes salt reabsorption and increases sweat tonicity due to higher levels of sodium and chloride.
In the intestinal and respiratory epithelium, the CFTR channel normally secretes chloride into the lumen and has an inhibitory effect on the ENaC, decreasing luminal sodium absorption. The resulting high levels of electrolytes help keep the mucus hydrated. Mutated CFTR reduces luminal chloride secretion and increases luminal sodium absorption, depleting the water content of the surface fluid layer overlying the mucosal cells. This contributes to the production of thick, viscid secretions that are low in both sodium and chloride.
CFTR function varies from tissue to tissue, and the tissue-specific functionality of CFTR accounts for the electrolyte differences between sweat and bronchial secretions

Most Common Cystic Fibrosis mutation
The most common CFTR gene mutation, Δ-F508, is associated with abnormalities in protein folding and processing that result in degradation of the aberrant protein before it reaches the apical surface of epithelial cells.
Pseudohypoparathyroidism description
Pseudohypoparathyroidism is a group of disorders characterized by end-organ resistance to parathyroid hormone (PTH) due to defects in the PTH receptor and downstream signaling pathways. Patients have hypocalcemia and hyperphosphatemia despite elevated PTH levels.
pseudohypoparathyroidism S&S
Albright hereditary osteodystrophy is an autosomal dominant form of pseudohypoparathyroidism associated with skeletal defects (eg, short stature, short metacarpal and metatarsal bones). It is caused by defects in GNAS1, which codes for the alpha subunit of the G protein (Gsα) that mediates the effects of PTH.
The manifestations of pseudohypoparathyroidism depend on whether the disease is maternally or paternally inherited because the expression of GNAS1 in various tissues is imprinted. Imprinting is an epigenetic phenomenon that causes tissue expression of certain genes dependent on maternal or paternal inheritance. Because the kidneys express only the maternal allele for GNAS1, paternal transmission causes the typical skeletal defects but with normal calcium, phosphorus, and PTH levels (termed pseudopseudohypoparathyroidism).
Caveat of Pseudohypoparathyroidism
Albright hereditary osteodystrophy is an autosomal dominant form of pseudohypoparathyroidism associated with skeletal defects (eg, short stature, short metacarpal and metatarsal bones). It is caused by defects in GNAS1, which codes for the alpha subunit of the G protein (Gsα) that mediates the effects of PTH.
The manifestations of pseudohypoparathyroidism depend on whether the disease is maternally or paternally inherited because the expression of GNAS1 in various tissues is imprinted. Imprinting is an epigenetic phenomenon that causes tissue expression of certain genes dependent on maternal or paternal inheritance. Because the kidneys express only the maternal allele for GNAS1, paternal transmission causes the typical skeletal defects but with normal calcium, phosphorus, and PTH levels (termed pseudopseudohypoparathyroidism).
Albright Hereditary Osteodystrophy
Albright hereditary osteodystrophy is an autosomal dominant form of pseudohypoparathyroidism associated with skeletal defects (eg, short stature, short metacarpal and metatarsal bones). It is caused by defects in GNAS1, which codes for the alpha subunit of the G protein (Gsα) that mediates the effects of PTH.
The manifestations of pseudohypoparathyroidism depend on whether the disease is maternally or paternally inherited because the expression of GNAS1 in various tissues is imprinted. Imprinting is an epigenetic phenomenon that causes tissue expression of certain genes dependent on maternal or paternal inheritance. Because the kidneys express only the maternal allele for GNAS1, paternal transmission causes the typical skeletal defects but with normal calcium, phosphorus, and PTH levels (termed pseudopseudohypoparathyroidism).
Describe mRNA post-transcriptional processing
- 5’ capping: 7-methylguanosine is added to the 5’ end of the primary mRNA transcript via a 5’-5’ triphosphate linkage. This modification helps stabilize mRNA in the cytosol.
- Poly(A) tail addition: Following transcription, a tail rich in adenine residues is added to the mRNA transcript by poly(A) polymerase. The poly(A) tail stabilizes the 3’ end of mRNA in the cytosol.
- Splicing “out” of introns: Introns are noncoding segments of a gene that are transcribed with exons into the primary mRNA transcript (pre-mRNA). Introns must be removed from pre-mRNA for protein translation to occur. This energy-dependent process is facilitated by small nuclear ribonucleoproteins (snRNPs).
Describe 5’ capping
7-methylguanosine is added to the 5’ end of the primary mRNA transcript via a 5’-5’ triphosphate linkage. This modification helps stabilize mRNA in the cytosol.
Describe Poly(A) tail addition
Following transcription, a tail rich in adenine residues is added to the mRNA transcript by poly(A) polymerase. The poly(A) tail stabilizes the 3’ end of mRNA in the cytosol.
Describe splicing
Splicing ‘out’ of introns: Introns are noncoding segments of a gene that are transcribed with exons into the primary mRNA transcript (pre-mRNA). Introns must be removed from pre-mRNA for protein translation to occur. This energy-dependent process is facilitated by small nuclear ribonucleoproteins (snRNPs).
Describe Allelic Heterogeniety
Allelic heterogeneity describes instances when different mutations at the same genetic locus cause similar phenotypes. The underlying concept is that more than one type of mutation is possible in a given gene, and different mutations can cause protein alterations or loss of function, resulting in disease. In the example, all patients have evidence of β-thalassemia, but 3 different mutations are identified that cause the disease.
Although the presentations are similar with allelic heterogeneity, the exact phenotype can vary based on the individual mutations. For instance, Duchenne and Becker muscular dystrophy are both frequently caused by deletions in the dystrophin gene. However, in Duchenne patients, this deletion results in a frameshift mutation that causes complete absence of the protein. In contrast, Becker patients have a preserved reading frame and produce a truncated protein with partial functionality that is responsible for the milder clinical course.
Allelic heterogeneity is not to be confused with genetic heterogeneity, where mutations of different genes cause similar phenotypes, or phenotypic heterogeneity, where mutations in the same gene result in markedly different phenotypes.
instances when different mutations at the same genetic locus cause similar phenotypes.
Allelic Heterogeneity
describe genetic heterogeneity
where mutations of different genes cause similar phenotypes
describe phenotypic heterogeneity
where mutations in the same gene result in markedly different phenotypes.
Epistasis Description
Epistasis refers to interactions between multiple genes that combine to create a new phenotype or mask/modify the phenotype of one of the genes. For example, patients with sickle cell anemia who also have a mutation causing persistence of high fetal hemoglobin levels often have a less severe clinical course.
Describe the Pathogenesis of Asthma

Anti-leukoptriene medications moa and use
Exercise intolerance, chest tightness, wheezing, and sensitivity to cold weather in this adolescent are strongly suggestive of exercise-induced asthma. As occurs with exposure to inhaled antigens in atopic patients, inspiration of high volumes of cold and dry air can trigger a similar, although typically less severe, inflammatory response involving TH2 lymphocytes, eosinophils, and mast cells.
The eosinophils and mast cells synthesize and release cysteinyl-containing leukotrienes (leukotriene C4, D4, and E4) that play an important role in asthma by inducing bronchospasm, bronchial mucus secretion, and bronchial edema. Anti-leukotriene medications (eg, montelukast, zafirlukast) inhibit leukotriene activity by blocking cysteinyl leukotriene receptors on bronchial smooth muscle, glandular epithelium, and vascular endothelium, and improve asthma symptoms.
Examples of Anti-leukotriene medications used in Asthma
- montelukast
- zafirlukast
ACE inhibitor Cough
ACE inhibitors (eg, lisinopril) treat hypertension by decreasing the conversion of angiotensin I to the vasoconstrictor angiotensin II.
They also inhibit ACE-mediated breakdown of bradykinin, a bronchoconstrictor, leading to cough in some patients
Bosentan Description
Endothelin receptors are located on vascular smooth muscle in the pulmonary arteries and induce vasoconstriction when stimulated. Endothelin receptor antagonists (eg, bosentan) are used to treat pulmonary arterial hypertension.
Histamines role in asthma
Histamine-1 receptor antagonists (eg, diphenhydramine, loratadine, cetirizine) are effective in treating allergic rhinitis and urticaria, but not in treating asthma.
Histamine does play an important role in asthma, but likely via interaction with histamine-4 (rather than histamine-1) receptors.
Clinical Manifestations of Hereditary Hemochromatosis
Skin
Hyperpigmentation (bronze diabetes)
Clinical Manifestations of Hereditary Hemochromatosis
Musculoskeletal
Arthralgia, arthropathy & chondrocalcinosis
Clinical Manifestations of Hereditary Hemochromatosis
Gastrointestinal
Elevated hepatic enzymes with hepatomegaly (early), cirrhosis (later) & increased risk of hepatocellular carcinoma
Clinical Manifestations of Hereditary Hemochromatosis
Endocrine
Diabetes mellitus, secondary hypogonadism & hypothyroidism
Clinical Manifestations of Hereditary Hemochromatosis
Cardiac
Restrictive or dilated cardiomyopathy & conduction abnormalities
Clinical Manifestations of Hereditary Hemochromatosis
Infections
Increased susceptibility to
- Listeria
- Vibrio vulnificus
- Yersinia enterocolitica
Hereditary Hemochromatosis susceptible infections
Increased susceptibility to Listeria, Vibrio vulnificus & Yersinia enterocolitica
Hereditary Hemochromatosis Description
Hemochromatosis is an autosomal recessive disease from the mutation in HFE which is characterized by excessive gastrointestinal absorption of iron. Affected individuals store excess iron in the form of hemosiderin within the dermis and various parenchymal organs. The disease is typically silent in early adulthood, presenting only after significant amounts of iron have been accumulated (usually age >40).
The pathophysiologic manifestations of hemochromatosis are determined by the tissues involved. Common manifestations include liver disease with hepatomegaly, diabetes mellitus secondary to pancreatic islet destruction, arthropathy, pituitary hormone deficiencies, and cardiomyopathy. Skin hyperpigmentation, often seen as a bronze discoloration, is also common and is due both to hemosiderin deposition in dermal macrophages and fibroblasts and to increased melanin production via an unknown mechanism.
Portal Venous System

Identify Structures


Pathogenesis of Portal Hypertension
Both chronic hepatitis C infection and chronic alcohol abuse are associated with hepatic cirrhosis. Cirrhosis is an irreversible process due to chronic injury to the hepatic parenchyma. In cirrhosis, hepatocyte necrosis and extensive fibrosis cause distortion of the hepatic vascular bed with formation of disorganized regenerative nodules. Disruption of the hepatic vasculature causes portal hypertension, leading to portosystemic anastomoses (eg, esophageal varices) and ascites.
The portal venous system is valveless; therefore, portal hypertension can cause retrograde flow of portal blood away from the liver and increased pressure within the splenic vein. This leads to congestion of the splenic red pulp and resulting splenomegaly.
Describe the pattern of blow flow to and from the liver

Describe the mechanism of ELISA
- Indirect enzyme-linked immunosorbent assay (ELISA) is a serologic test that identifies the presence of serum antibody directed against a known target antigen. The steps are performed as follows:
- A known antigen (eg, parvovirus B19 viral protein) is fixed to the surface of a well.
- Patient serum is added. If present, antigen-specific antibodies bind the antigen and remain fixed to the well. The plate is then washed to remove unbound patient antibodies.
- Anti-human immunoglobulin antibody coupled to a substrate-modifying enzyme (eg, peroxidase) is then added. This antibody-enzyme conjugate binds to antigen-bound antibodies in the wells. The plate is again washed.
- Finally, a substrate, which is modified by the enzyme to elicit a detectable signal such as a color change, is added. If the assay is quantitative, the intensity of color change is proportional to the amount of antibody present in the patient’s serum.
A 44-year-old man comes to the emergency department due to a rash on his left outer thigh. The patient is an industrial worker and sustained an accidental iron burn to this area. The burn site became significantly more inflamed, and a yellowish crust developed. The patient has no past medical history and takes no medications. Temperature is 37.1 C (98.8 C). Physical examination shows plaques and thick crusts with golden hue on his left outer thigh, as seen in the image below.
What organism is most likely causing the patient’s symptoms?

Staphylococcus aureus
This patient has prolonged erythema and a yellow (“honey”) crust on a cutaneous wound, classic findings of impetigo. The most common causes are Staphylococcus aureus and Group A Streptococcus. In cases of impetigo caused by S aureus, bullae may form due to toxin production (bullous impetigo). Impetigo can also complicate chronic inflammatory lesions, such as eczema (secondary impetigo).
Bacteroides fragilis most common infections
Bacteroides fragilis is most commonly associated with intraabdominal abscesses following abdominal trauma or surgery. It is also a cause of endometritis and intraabdominal abscesses following gynecologic procedures.
Group B Strep most common infections
Group B Streptococcus is most classically associated with neonatal sepsis, chorioamnionitis, and endometritis.
Pseudomonas aeruginosa most common skin infections
Pseudomonas aeruginosa often underlies skin diseases like ecthyma gangrenosum, hot tub folliculitis, pyoderma, green nail syndrome, and botryomycosis.
Whats this?
Pyoderma Gangrenosum (P. aeruginosa)

S. epidermidis in a wound culture
Staphylococcus epidermidis is a component of normal skin flora and is not commonly associated with skin disease. If found in a wound culture, S epidermidis is generally regarded as a contaminant.
Bacterial drug efflux pumps
Efflux pumps are transport proteins that excrete toxic substances (eg, antibiotics) from the cytoplasm/periplasm of bacteria into the external environment. They are a common cause of drug (or multidrug) resistance. Efflux pumps are energy dependent and operate using ATP, sodium gradients, or proton electrochemical gradients.
Bacteria generate proton electrochemical gradients by pumping hydrogen ions out of the cell, resulting in a transmembrane pH gradient of 2-3. Hydrogen ions can then travel down the gradient, releasing energy which can be used to generate ATP (via ATP synthase) or power efflux pumps to extrude toxic substances. High pH agars can neutralize proton gradients by raising the pH of the external environment, thereby limiting the hydrogen concentration difference between the exterior and interior of the cell. The reduction in ciprofloxacin MIC with a high pH agar indicates that the underlying source of antibiotic resistance was an efflux pump that utilized the proton gradient for energy.

An 8-year-old boy with cystic fibrosis is hospitalized due to fever, chills, and cough productive of greenish sputum. He has been treated for bacterial pneumonia on several occasions. Temperature is 38.8 C (101.8 F). Physical examination reveals dullness to percussion and bronchial breath sounds over the right lung base. Sputum cultures grow Pseudomonas aeruginosa, which is resistant to ciprofloxacin with a high minimum inhibitory concentration. Repeat antibiotic sensitivity testing in a growth medium with a higher pH lowers the minimum inhibitory concentration of the drug. Which of the following is the most likely mechanism of ciprofloxacin resistance in this bacterial isolate?
Efflux pumps are transport proteins that excrete toxic substances (eg, antibiotics) from the cytoplasm/periplasm of bacteria into the external environment. They are a common cause of drug (or multidrug) resistance. Efflux pumps are energy dependent and operate using ATP, sodium gradients, or proton electrochemical gradients.
Bacteria generate proton electrochemical gradients by pumping hydrogen ions out of the cell, resulting in a transmembrane pH gradient of 2-3. Hydrogen ions can then travel down the gradient, releasing energy which can be used to generate ATP (via ATP synthase) or power efflux pumps to extrude toxic substances. High pH agars can neutralize proton gradients by raising the pH of the external environment, thereby limiting the hydrogen concentration difference between the exterior and interior of the cell. The reduction in ciprofloxacin MIC with a high pH agar indicates that the underlying source of antibiotic resistance was an efflux pump that utilized the proton gradient for energy.
Mechanism of Fluoroquinolone Resistance
Fluoroquinolones inhibit bacterial DNA synthesis by binding DNA gyrase and topoisomerase.
Alteration to the fluoroquinolone binding site on these enzymes is another common mechanism of fluoroquinolone resistance.
Mechanism of resistance to TMP-SMX
Resistance to antibiotics (eg, trimethoprim-sulfamethoxazole) that impede metabolic processes (eg, folate synthesis) occurs when bacteria overproduce the antimicrobial target.
Mechanism of resistance to beta lactam antibiotics
Beta lactamases are enzymes produced by bacteria that destroy the beta-lactam ring of penicillins and carbapenems, making them ineffective.
Antibiotics gain entry to the cytoplasm through the bacterial cell wall and cell membrane. Impaired antibiotic penetrance is a common cause of drug resistance. However, this mechanism of resistance is primarily countered by drugs that impair cell wall synthesis
Physical examination of a girl shortly after birth shows a head circumference at the 90th percentile, mid-face hypoplasia, and humeral and femoral shortening. The hands have shortened digits and a space between the third and fourth digits. The patient was born to a 35-year-old woman who had an uncomplicated pregnancy. However, the mother did not have prenatal care until 14 weeks gestation as she was unaware she was pregnant. The girl’s parents have no significant medical history. Which of the following is the most likely cause of this patient’s presentation?
FGFR3 gene mutation
Achondroplasia Pathophysiology
Achondroplasia is an autosomal dominant disorder caused by a gain-of-function point mutation on the fibroblast growth factor receptor 3 (FGFR3) gene.
FGFR3 normally acts to inhibit excessive cartilage proliferation, particularly in the long bones.
In achondroplasia, FGFR3 becomes constitutively activated, leading to severely restricted chondrocyte proliferation in growth plate cartilage and decreased endochondral ossification.
Ninety percent of mutations are de novo (as seen in this case); 10% are inherited from an affected parent.
Physical Features of Achondroplasia
Skeletal abnormalities are present at birth and include rhizomelia (shortened proximal extremities) and brachydactyly (shortened digits) in a trident configuration (space between 3rd and 4th digits).
Craniofacial features include macrocephaly, midface hypoplasia, and frontal bossing.
Patients have an increased risk of spinal stenosis, or narrowing of the spinal canal/intervertebral foramina, and resultant nerve root compression due to bony and connective tissue abnormalities.
This complication usually presents with proximal lower extremity weakness/paresthesia that is exacerbated by activity.

Osteogenesis imperfecta mutation
Most patients with osteogenesis imperfecta have a mutation of the COL1A1 gene leading to defective type I collagen production and short stature
Osteogenesis imperfecta S&S
Femoral bowing and recurrent pathological fractures can occur prenatally and throughout childhood.
Patients classically have blue sclerae

Phenotype of Fragile X Syndrome

Fragile X Syndrome Mutation
Fragile X syndrome (mutation in the fragile X mental retardation 1 [FMR1] gene on the long arm of the X chromosome)
Phenotype of fetal alcohol syndrome

Isotretinoin teratogenic implication
contraindicated in pregnancy
Craniofacial malformations include ear anomalies (eg, small or no ears), micrognathia, depressed nasal bridge, and hypertelorism (large distance between the eyes).
Cardiac (eg, transposition of the great arteries) and central nervous system (eg, hydrocephalus, microcephaly) defects can also be seen
A 9-month-old who has recurrent infections is found to have an abnormal gene coding for a cytoplasmic tyrosine kinase. Normally, this tyrosine kinase is active in the bone marrow within CD19+ cells, leading to normal maturation and effective functioning. The abnormal gene responsible for this patient’s condition can be mapped to which of the following?
X-chromosome
This is X-linked agammaglobulinemia
X-linked agammaglobulinemia mutation
X-linked agammaglobulinemia (XLA), also known as Bruton agammaglobulinemia, is a rare genetic condition caused by inactivating mutations in the Bruton tyrosine kinase (BTK) gene on the X chromosome
This causes impaired B-cell maturation & immunoglobulin production
X-linked agammaglobulinemia pathophysiology
X-linked agammaglobulinemia (XLA), also known as Bruton agammaglobulinemia, is a rare genetic condition caused by inactivating mutations in the Bruton tyrosine kinase (BTK) gene on the X chromosome.
BTK is a protein found in CD19+ B cells. It is involved in signal transduction from the pre-B cell receptor that forms after successful immunoglobulin heavy chain rearrangement during B-lymphocyte maturation.
Without this signal, clonal expansion of pre-B cells is severely limited, resulting in markedly reduced plasma cell formation and antibody production.
X-linked agammaglobulinemia S&S
Due to impaired humoral immunity, patients are at increased risk of recurrent infections (eg, sinopulmonary) by encapsulated organisms such as Haemophilus influenzae type B and Streptococcus pneumoniae. Infections typically develop in late infancy after maternally derived IgG has waned (around age 3-6 months).
Laboratory evaluation of XLA reveals normal T-cell concentrations (CD3+ lymphocytes) but low or absent mature B cells (CD19+ and CD20+ lymphocytes). Patients also have very low serum immunoglobulins and impaired antibody response to vaccines.
- Recurrent sinopulmonary & gastrointestinal infections at age >3-6 months
- Chronic enteroviral infection
- Small or absent lymphoid tissue
- (eg, tonsils, adenoids)
X-linked agammaglobulinemia Labs
↓ Immunoglobulins & antibody response to vaccines
Flow cytometry: ↓ CD19+ B cells
& normal T cells
X-linked agammaglobulinemia Tx
Immunoglobulin replacement therapy
Prophylactic antibiotics if severe
Common diseases associated with genetic mutations on chromosome 16
- polycystic kidney disease
- tuberous sclerosis
Common disease associated with chromosome 20
maturity onset diabetes of the young type 1
Syndromes caused by meiotic nondisjunction
Meiotic nondisjunction is the cause of most chromosomal trisomy such as
- Down syndrome (trisomy 21)
- Edwards syndrome (trisomy 18)
- Patau syndrome (trisomy 13).
- Although meiotic nondisjunction of the sex chromosomes can cause Klinefelter syndrome (XXY), patients will have 47 chromosomes and male phenotype.
Describe the process of insulin synthesis and secretion

N-terminal signal sequences importance
Ribosomes facilitate the translation of mRNA into protein. This process begins in the cytosol, when mRNA binds to a ribosome and initiates translation. Proteins destined for the endoplasmic reticulum possess N-terminal peptide signal sequences that identify them as such. These N-terminal sequences are translated in the cytosol and are rapidly recognized by signal recognition particles (SRPs), which halt translation and target the ribosome to protein pores in the rough endoplasmic reticulum (RER).
Once the ribosome is bound to the RER, the SRP dissociates and translation proceeds with the polypeptide being fed into the RER through the membrane pore. Signal sequences that call for protein targeting to the RER are composed of 15-20 amino acid residues, most of which are hydrophobic. Deletion of this hydrophobic signal sequence would cause failure of SRP binding and inappropriate protein accumulation in the cytosol.
A 7-day-old boy is brought to the emergency department for evaluation of vomiting. He was born to a 32-year-old woman at term. Over the past 2 days, the mother has noticed the infant is less interested in feeding, and today he has vomited a few times. Temperature is 37 C (98.6 F), pulse is 190/min, and respirations are 42/min. The infant is lethargic on examination. No murmurs are noted, and breath sounds are equal bilaterally. The abdomen is soft, and there is no hepatomegaly. Pulses are weak, and capillary refill is delayed. Laboratory results are as follows:
The enzyme that is most likely deficient in this patient requires which of the following cofactors for proper functioning?

Thiamine
This infant’s symptoms of feeding intolerance, vomiting, and lethargy combined with metabolic acidosis and hypoglycemia are concerning for an inborn error of metabolism. Increased levels of the branched-chain amino acids (BCAAs: leucine, isoleucine, and valine) as well as alloisoleucine (a stereoisomer of isoleucine) are characteristic of maple syrup urine disease (MSUD), also known as branched-chain ketoaciduria.
Maple Syrup Urine disease pathophysiology
Patients with MSUD have a defect in the branched-chain alpha-keto acid dehydrogenase complex, an enzyme that is dependent on thiamine (vitamin B1).
This defect causes a buildup of BCAAs and their alpha-keto acid analogs, resulting in ketoacidosis.
Excessive plasma BCAAs affect neurotransmitter synthesis, causing CNS toxicity manifesting with dystonia, lethargy, seizures, and/or vomiting.
BCAA metabolites in the urine cause a characteristic sweet odor.
Hypoglycemia may also be present, likely from decreased gluconeogenesis from dysfunctional amino acid breakdown along with poor feeding.
This can progress to dehydration, suggested by weak pulses and delayed capillary refill

Maple Syrup Urine disease Tx
early restriction of BCAAs in the diet.
Ascorbic acid is involved in
Ascorbic acid (vitamin C) acts as an electron donor and is involved in multiple physiologic processes, including collagen synthesis and fatty acid transport
Impaired collagen synthesis from vitamin C deficiency results in scurvy (easy bruising, bleeding, impaired wound healing, arthralgias).
Folic Acid is involved in
Folic acid (vitamin B9) has a crucial role in single-carbon transfer reactions in the form of tetrahydrofolate. It is required for the synthesis of purines, thymine, and certain amino acids.
Folic acid deficiency can cause neural tube defects in the fetus as well as megaloblastic anemia in adults.
Pyridoxine is involved in
Pyridoxine (vitamin B6) functions as a cofactor in numerous reactions, including transamination, decarboxylation, condensation, and deamination.
Vitamin B6 deficiency may present with oral inflammation (eg, glossitis, stomatitis, cheilitis), microcytic anemia, and dermatitis.
Retinol is involved in
Retinol (vitamin A) is converted to retinaldehyde and retinoic acid. Although vitamin A does not function as a coenzyme, it is required for normal vision and maintenance of epithelial differentiation.
Vitamin A deficiency causes night blindness, follicular hyperkeratosis, and xerophthalmia.
List of Branched Chain Amino Acids
- leucine
- valine
- isoleucine
Adult form of Hemoglobin
The major form of adult hemoglobin is hemoglobin A (2 alpha and 2 beta chains)
Fetal form of hemoglobin
primary fetal form is hemoglobin F (2 alpha and 2 gamma chains)
Degress of Alpha thalassemia

Alpha Thalassemia minima gene loss
1 gene loss
(αα/α−)
Alpha thalassemia minor gene loss
2 gene loss
(αα/−−) or (α−/α−)
Hemoglobin H disease gene loss
3 gene loss
alpha thalassemia
(α−/−−)
Hydrops fetalis,
hemoglobin Barts
gene loss
4 gene loss
alpha thalassemia
(−−/−−)
Alpha Thalassemia minima clinical features
- Asymptomatic
- silent carrier
Alpha thalassemia minor Clinical features
Mild microcytic anemia
Hemoglobin H disease Clinical features
Chronic hemolytic anemia
Hydrops fetalis,
hemoglobin Barts Clinical features
- High-output cardiac failure,
- anasarca (a serious condition in which there is a generalized accumulation of fluid in the interstitial space)
- death in utero
Epidemiology of Alpha Thalssemia
most common among Southeast Asian populations
hemoglobin Barts structure
4 gamma chains
What are Howell-Jolly Bodies?
Howell-Jolly bodies, remnants of red blood cell nuclei, are normally removed by a healthy spleen. They are seen in patients with asplenia (eg, surgical removal of the spleen) or splenic dysfunction (eg, sickle cell disease).
Hemoglobin Barts pathology
Hemoglobin Barts has an extreme affinity for oxygen (>10 times more than hemoglobin A) and is unable to release oxygen to the tissues. The severe hypoxia results in hydrops fetalis (anasarca, ascites, pleural/pericardial effusions) and intrauterine death
Smear of Megaloblastic anemia
Peripheral smear reveals macrocytic red blood cells and hypersegmented neutrophils.

Causes of megaloblastic anemia
Megaloblastic anemia is seen in vitamin B12 and folate deficiency.
Sickle Cell smear

Hereditary Spherocytosis smear

Hereditary Spherocytosis features
Hereditary spherocytosis, usually an autosomal dominant condition, is a red blood cell membrane defect characterized by spherocytes on peripheral blood smear. Typical features include neonatal jaundice and hepatosplenomegaly due to chronic hemolysis.
Alpha Thalassemia minor smear
microcytic cells as a result of imbalanced globin chain production resulting in decreased total hemoglobin in red cells.

Patients with alpha thalassemia minor
Patients with alpha-thalassemia minor have a mild anemia with hypochromic and microcytic cells.
\However, offspring of 2 parents with alpha-thalassemia minor are at risk for absent alpha globin production–the most severe form of alpha-thalassemia– which leads to hemoglobin Barts formation and death in utero from hydrops fetalis (anasarca, ascites, and effusions).

A 34-year-old man comes to the clinic to evaluate infertility. He and his wife have been trying to conceive for 2 years. His wife completed a full anatomic and hormonal evaluation with normal results. The patient had normal puberty and reports normal libido and erectile function. He takes no medications. Physical examination shows normal secondary sexual characteristics and bilaterally descended testes that are slightly smaller than normal. Serum concentrations of testosterone and LH are normal. Testicular biopsy reveals that the testosterone concentration in his seminiferous tubules and epididymis is abnormally low. Dysfunction of which of the following cells is the most likely cause of this patient’s findings?
Sertoli Cells
he seminiferous tubules and epididymis must maintain high concentrations of testosterone relative to the circulation for spermatogenesis and sperm maturation to occur. These high concentrations are normally maintained by androgen-binding protein (ABP) within the seminiferous tubule. ABP binds testosterone and dihydrotestosterone, making these hormones less lipophilic and reducing diffusion out of the luminal fluid. ABP is synthesized by Sertoli cells in response to FSH and secreted into the seminiferous tubule lumen.
This patient has normal circulating testosterone levels, suggesting normal function of the hypothalamus-pituitary-gonad axis and normal secretory function of the Leydig cells. However, the low concentration of testosterone in the seminiferous tubules suggests Sertoli cell dysfunction with inadequate production of ABP
A clinical researcher is studying the metabolic effects of a new hormone analogue. In an experiment, serum glucose levels and activity of several hepatic enzymes are measured before and after the hormone analogue is administered to an animal. It is determined that this agent leads to increased activity of phosphorylase kinase and phosphoenolpyruvate carboxykinase in the liver, resulting in rapid elevation of blood glucose levels. This new agent most likely acts through which of the following proteins in hepatocytes?
Gs protein
The new agent described in the experiment likely represents an analogue of glucagon, a hormone that promotes glycogenolysis and gluconeogenesis in the liver. Glucagon binds to G protein-coupled receptors on hepatocytes, activating Gs, which in turn stimulates adenylate cyclase to increase intracellular cyclic AMP (cAMP) levels. cAMP activates protein kinase A, which leads to the activation of key enzymes in glycogenolysis (eg, glycogen phosphorylase, phosphorylase kinase) and gluconeogenesis (eg, pyruvate carboxylase, phosphoenolpyruvate carboxykinase).
Epinephrine produces a similar metabolic effect in hepatocytes and muscle cells by binding to G protein-coupled beta-2 adrenergic receptors. Beta-2 receptor stimulation results in the sequential activation of Gs and the adenylate cyclase second messenger system, leading to increased glycogenolysis (liver, muscle) and gluconeogenesis.
Gq is involved in
Gq is activated by hormone binding to alpha-1 adrenergic and V1 (vasopressin) receptors. It then stimulates the phosphatidylinositol second messenger system
A 16-year-old girl is evaluated for heat intolerance and excessive sweating. She has had excessive sweating in her axillae, even with mild heat or emotional stimuli, leading to skin maceration. The patient feels embarrassed as the condition has caused staining of her clothes on many occasions. She has used antiperspirants and anticholinergic medications, but they have not provided much relief. Past medical history is negative for other neurologic conditions, thyroid disorders, and cardiac conduction system disease. Physical examination is unremarkable. Extensive laboratory testing, including thyroid function tests, has not identified a correctable cause for her sweating. Surgical interruption of which of the following structures is most likely to help this patient’s condition?
Thoracic Sympathetic trunk

This patient with excessive sweating out of proportion to normal stimuli has hyperhidrosis. Sweating is a function of the sympathetic nervous system, and sympathetic hyperactivity can lead to increased sweating, particularly affecting the palms, soles, and axillae. Sympathetic postganglionic cholinergic neurons innervate eccrine and apocrine (though not sebaceous) sweat glands.
Systemic anticholinergic medications (eg, oxybutynin), local anticholinergic injectable medications (eg, botulinum toxin), or surgical sympathectomy may be used to treat hyperhidrosis. Surgical sympathectomy for primary focal hyperhidrosis of the axilla uses electrocoagulation to target the thoracic sympathetic trunk at the T2 sympathetic segment.
Hyaline cartilage description
Hyaline cartilage is characterized histologically by dispersed chondrocytes in a matrix of type II collagen and proteoglycans.
Blood vessels are absent, and articular cartilage also lacks a perichondrium (ie, fibrous layer of undifferentiated cells that can form chondroblasts to allow for appositional growth)

Osteoarthritis progression
Osteoarthritis (OA) is a chronic condition characterized by the progressive erosion of articular cartilage, primarily within the large weight-bearing joints of the lower extremity and distal joints of the hands. It typically progresses with age and is accelerated in patients with excessive mechanical stresses (eg, obesity, joint deformities). The etiology of OA is multifactorial, with excessive biomechanical stress and increased intraarticular metalloprotease activity as the major contributors to cartilage destruction.
As OA progresses, the collagen and proteoglycan components of articular cartilage are degraded and are replaced by increased water content. In advanced OA, apoptosis of chondrocytes can lead to fragility of the articular cartilage, resulting in fragmentation of the cartilage and the formation of loose bodies and subchondral cysts in the underlying bone. These fragments can interfere with the normal motion of the joint and cause a locking or catching sensation.
Identify Structures


Gubernaculum becomes
During embryonic development, a ligamentous band of tissue (the gubernaculum) attaches to the inferior portion of the gonads in both sexes. As the fetus develops, the gubernaculum shortens, thereby pulling the gonads from their original position high in the retroperitoneum down into the pelvis in females and into the scrotum in males. In adult males, the gubernaculum persists as the scrotal ligament, which secures the testes to the scrotal floor. In adult females, the inferior portion of the gubernaculum becomes the round ligament of the uterus (ie, ligamentum teres uteri), which passes through the inguinal canal and out to attach to the labia majora. The superior portion persists as the uteroovarian ligament, which connects the uterus to the ovary

A 32-year-old woman comes to the emergency department due to an acute headache, palpitations, flushing, and blurred vision for the past 30 minutes. She has had several similar episodes over the last 6 weeks, and the symptoms spontaneously resolve after 30-60 minutes. The patient has no significant medical history and takes no medications. She does not use tobacco, alcohol, or illicit drugs. Blood pressure is 210/112 mm Hg and pulse is 115/min and regular. On physical examination, the patient is diaphoretic. Chest and abdominal examinations show no abnormalities. Imaging studies reveal a 4-cm para-aortic mass at the level of the aortic bifurcation. Which of the following is most likely to be elevated in this patient?
Urinary metanephrines
This patient with episodic headaches, palpitations, and severe hypertension has a catecholamine-secreting tumor. Imaging findings are consistent with a paraganglioma arising from chromaffin cells at the organ of Zuckerkandl. Similar tumors arising in the adrenal medulla are termed pheochromocytomas. These tumors hypersecrete epinephrine, norepinephrine, and occasionally dopamine, which result in the characteristic clinical symptoms.
Epinephrine and norepinephrine are metabolized to metanephrine and normetanephrine, respectively, by catechol-O-methyltransferase and subsequently to the biologically inactive breakdown product vanillylmandelic acid by monoamine oxidase. As a result, plasma and urinary concentrations of catecholamines, metanephrines, and vanillylmandelic acid are elevated in patients with catecholamine-secreting tumors.
Primary breakdown product of Serotonin
5-Hydroxyindoleacetic acid is the primary breakdown product of serotonin. Elevated levels are seen in intestinal carcinoid tumors, which secrete large quantities of serotonin and present with flushing, diarrhea, and abdominal pain.
21 hydroxylase deficiency labs
Elevated 17-hydroxyprogesterone levels occur in congenital adrenal hyperplasia due to 21-hydroxylase deficiency.
This condition is characterized by impaired glucocorticoid and mineralocorticoid production with shunting of steroid precursors toward androgen production.
Women with nonclassic (late-onset) 21-hydroxylase deficiency can develop acne, hirsutism, and oligomenorrhea.
Elevated 17-hydroxyprogesterone levels occur in congenital adrenal hyperplasia due to 21-hydroxylase deficiency. This condition is characterized by impaired glucocorticoid and mineralocorticoid production with shunting of steroid precursors toward androgen production. Women with nonclassic (late-onset) 21-hydroxylase deficiency can develop acne, hirsutism, and oligomenorrhea.

This patient’s presentation with sudden-onset shortness of breath, chest pain, and a tender, swollen calf is strongly suggestive of pulmonary embolism (PE) secondary to deep vein thrombosis. His age (>40), history of smoking, and occupation as a truck driver (prolonged immobility) are all risk factors for deep vein thrombosis.
Significant PE increases dead-space ventilation and causes a consequent ventilation-perfusion (V/Q) mismatch. As the embolus leads to redistribution of blood through the rest of the pulmonary circulation, the volume of blood flowing past the remaining accessible alveoli becomes too great for complete oxygenation to occur, and hypoxemia results.
The PE also triggers hyperventilation, likely due to release of irritating inflammatory mediators and a central response to dyspnea. Because nearly all O2 in the blood is carried by hemoglobin and hemoglobin is nearly fully saturated in regions with normal V/Q ratio, there is minimal capacity for high V/Q regions to increase blood O2 content much further. However, because CO2 is carried in the blood as HCO3- and is not protein bound, CO2 removal is more directly dependent on ventilation and there is large capacity for high V/Q regions to exhale additional CO2. Therefore, the result of the hyperventilation is hypocapnia with respiratory alkalosis (high pH) and persistent hypoxemia, which is the typical presentation of acute PE.

Pulonary Embolism pathophysiology
This patient’s presentation with sudden-onset shortness of breath, chest pain, and a tender, swollen calf is strongly suggestive of pulmonary embolism (PE) secondary to deep vein thrombosis. His age (>40), history of smoking, and occupation as a truck driver (prolonged immobility) are all risk factors for deep vein thrombosis.
Significant PE increases dead-space ventilation and causes a consequent ventilation-perfusion (V/Q) mismatch. As the embolus leads to redistribution of blood through the rest of the pulmonary circulation, the volume of blood flowing past the remaining accessible alveoli becomes too great for complete oxygenation to occur, and hypoxemia results.
The PE also triggers hyperventilation, likely due to release of irritating inflammatory mediators and a central response to dyspnea. Because nearly all O2 in the blood is carried by hemoglobin and hemoglobin is nearly fully saturated in regions with normal V/Q ratio, there is minimal capacity for high V/Q regions to increase blood O2 content much further. However, because CO2 is carried in the blood as HCO3- and is not protein bound, CO2 removal is more directly dependent on ventilation and there is large capacity for high V/Q regions to exhale additional CO2. Therefore, the result of the hyperventilation is hypocapnia with respiratory alkalosis (high pH) and persistent hypoxemia, which is the typical presentation of acute PE.
